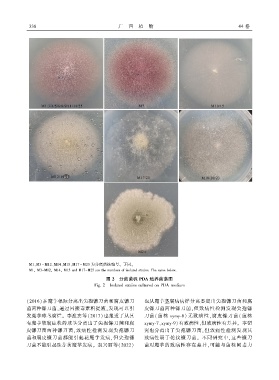

Page 136 - 《广西植物》2024年第2期
P. 136
3 3 8 广 西 植 物 44 卷
M1、M3~ M12、M14、M15、M17~ M25 为分离菌株编号ꎮ 下同ꎮ
M1ꎬ M3-M12ꎬ M14ꎬ M15 and M17-M25 are the numbers of isolated strains. The same below.
图 2 分离菌株 PDA 培养菌落图
Fig. 2 Isolated strains cultured on PDA medium
(2016)在魔芋根际分离出尖孢镰刀菌和腐皮镰刀 也从魔芋茎腐病病样分离鉴定出尖孢镰刀菌和腐
菌两种镰刀菌ꎬ通过回接毒素粗提液ꎬ发现可以引 皮镰刀菌两种镰刀菌ꎬ但致病性检测发现尖孢镰
发魔芋球茎腐烂ꎮ 李迎宾等(2017) 也报道了从具 刀菌( 菌株 xymy ̄8) 无致病性ꎬ腐皮镰刀菌( 菌株
有魔芋软腐症状的球茎分离出了尖孢镰刀菌和腐 xymy ̄7、xymy ̄9)有致病性ꎬ但致病性有差异ꎮ 本研
皮镰刀菌两种镰刀菌ꎬ致病性检测发现尖孢镰刀 究也分离出了尖孢镰刀菌ꎬ但致病性检测发现其
菌和腐皮镰刀菌都能引起花魔芋发病ꎬ但尖孢镰 致病性弱于轮纹镰刀菌ꎮ 不同研究中ꎬ这些镰刀
刀菌不能引起珠芽黄魔芋发病ꎮ 赵兴丽等(2022) 菌对魔芋的致病性存在差异ꎬ可能与菌株间毒力